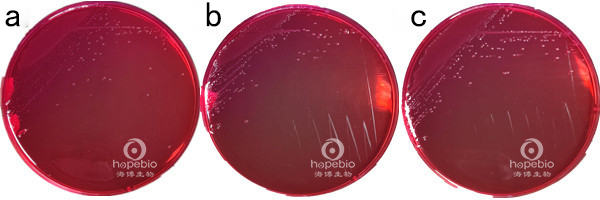
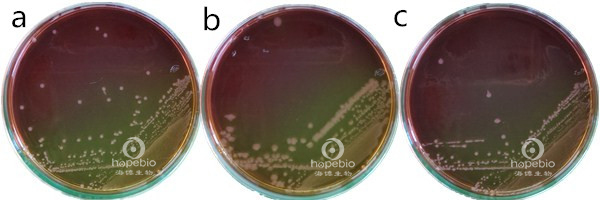
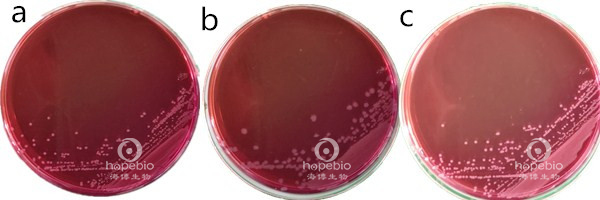

海博微信公众号
海博微信公众号
 海博天猫旗舰店
海博天猫旗舰店


 海博微信公众号
海博微信公众号
 海博天猫旗舰店
海博天猫旗舰店




一、样品处理及增菌
1.样品的处理
以无菌操作取样25g(mL)加入装有灭菌225mL志贺氏菌增菌肉汤的均质容器中,常用均质容器有均质杯、锥形瓶、均质袋。如图1-1。

a均质袋;b锥形瓶
图1-1均质容器
均质杯多用于不易溶解的固体样品均质,可将固体样品切割搅拌均匀;均质袋可置于拍击式均质器中均质固体,也常用于液体的均质;锥形瓶可置于摇床中,常用于液体的均质。
2.增菌
均质后的样品置于41.5℃±1℃,厌氧培养16h-20h。厌氧培养可使用厌氧培养箱、厌氧培养盒和厌氧培养袋(如图1-2-1)等。

a均质袋在厌氧袋中培养;b锥形瓶在厌氧袋中培养
图1-2-1厌氧袋培养
志贺氏菌在志贺氏增菌肉汤中生长浑浊,如图1-2-2所示。

a空白管;b福氏志贺氏菌ATCC12022;
c宋内志贺氏菌ATCC25931;d痢疾志贺氏菌CMCC51252
图1-2-2
二、志贺氏菌的分离
取增菌后的志贺氏增菌液分别划线接种于XLD琼脂平板和MAC琼脂平板或志贺氏显色培养基平板上,于36℃±1℃需氧培养20h-24h。若出现的菌落不典型或菌落较小不易观察,则继续培养至48h再进行观察。
1.XLD琼脂平板
志贺氏菌在XLD琼脂平板上的菌落特征为粉色至无色,半透明、光滑、湿润、圆形、边缘整齐或不齐菌落(如图2-1所示)。志贺氏菌大多不发酵木糖、乳糖和蔗糖,可与发酵此三种糖类的细菌(如大肠黄色菌落)区分;志贺氏菌不产硫化氢,可与产硫化氢的细菌(如大部分沙门等)区分。
a福氏志贺氏菌ATCC12022;b宋内志贺氏菌ATCC25931;c痢疾志贺氏菌CMCC51252
图2-1志贺氏菌在XLD琼脂平板上的生长情况
2.MAC或志贺显色培养基
志贺氏菌在MAC琼脂平板上的菌落特征为微黄色菌落,半透明、光滑、湿润、圆形、边缘整齐或不齐菌落(如图2-2-1所示)。志贺氏菌大多不发酵乳糖产碱,故菌落颜色为黄色,可与发酵乳糖产酸(菌落颜色为红色,或有胆盐沉淀环)的细菌区分。部分宋内志贺氏菌迟缓发酵乳糖,若培养时间过长会产生粉色菌落,混淆结果。
a福氏志贺氏菌ATCC12022;b宋内志贺氏菌ATCC25931;c痢疾志贺氏菌CMCC51252
图2-2-1志贺氏菌在MAC琼脂平板上的生长情况
志贺氏菌在志贺氏显色培养基平板上的菌落特征为白色或无色,半透明、光滑、湿润、圆形、边缘整齐或不齐菌落(如图2-2-2所示),有些宋内志贺氏菌有蓝色中心。
a福氏志贺氏菌ATCC12022;b宋内志贺氏菌ATCC25931;c痢疾志贺氏菌CMCC51252
图2-2-2志贺氏菌在志贺氏显色培养基平板上的生长情况
三、初步生化试验
自上述选择性平板上分别挑取2个以上典型或可疑菌落,分别接种三糖铁琼脂(TSI)、半固体和营养琼脂斜面一管,置于36℃±1℃需氧培养20h-24h。
1.三糖铁琼脂
志贺氏菌在三糖铁琼脂TSI中:
①斜面产碱呈红色且底层产酸呈黄色(发酵葡萄糖,不发酵乳糖、蔗糖),如图3-1-b、c、d;
②不产气(福氏志贺氏菌6型可产生少量气体),可对比图3-1-e产气结果进行判断;
③不产硫化氢,可对比3-1-f产硫化氢(可观察到黑色)结果进行判断。

a空白管;b福氏志贺氏菌ATCC12022;c宋内志贺氏菌ATCC25931;
d痢疾志贺氏菌CMCC51252;e大肠埃希氏菌ATCC25922;f沙门氏菌ATCC14028
图3-1志贺氏菌在TSI琼脂斜面上的生长情况
2.半固体培养基
志贺氏菌在半固体培养基中无动力,如图3-2-b、c、d所示,3-2-e、f为有动力菌株实验结果。

a空白管;b福氏志贺氏菌ATCC12022;c宋内志贺氏菌ATCC25931;d痢疾志贺氏菌CMCC51252
e大肠埃希氏菌ATCC25922;f沙门氏菌ATCC14028
图3-2志贺氏菌在半固体琼脂上的生长情况
志贺氏菌在半固体培养基中无动力,只沿穿刺线生长;对比之下,大肠埃希氏菌和沙门氏菌在半固体培养基中有动力,在培养基中扩散生长,观察培养基会发现穿刺线周围呈现“混浊”状态。
四、后续鉴定
确定符合TSI和半固体培养基中志贺氏菌生化反应结果的可疑菌落,挑取其在已培养的营养琼脂斜面上生长的菌苔,进行后续生化实验和血清学鉴定。
五、注意事项
1、取检样时应保证无菌操作,避免引入污染:①取样工具(药匙、枪头等)、均质容器无菌处理;②取样操作、后续接种操作在无菌环境中进行。
2、在选择均质容器时,除了要考虑均质容器的功能性,还要兼顾后续的厌氧培养条件能否实现。如果配备厌氧培养箱,则可自由选择均质容器;若只能使用厌氧培养盒或厌氧培养袋,则需考虑到均质容器的大小等,以确保厌氧增菌能正常进行。
3、使用志贺氏增菌肉汤增菌时,需注意培养温度为41.5℃±1℃且厌氧培养,主要是因为志贺氏菌在此条件下并在含有低浓度碳水化合物的培养基中生长速度超过大肠菌群,以及志贺氏菌在提高温度时对新生霉素相对耐受。
3、TSI培养基要制成高层斜面,便于后续试验观察,高层斜面是指斜面与底层高度约2:3,即底部高约3cm,斜面长度2cm。
4、在进行半固体琼脂穿刺试验时,接种针不是总能沿穿刺路径原路返回,导致穿刺路线会侧向扩大。进行结果观察时需注意,半固体培养基的阳性结果是穿刺线周围的培养基会呈现“混浊”状态,即有菌的运动和生长,不是单纯的侧向扩增。
5、部分不产硫化氢的沙门氏菌是志贺氏菌分离鉴定过程中的干扰菌,其在XLD、MAC和志贺氏显色培养基上生长状态类似,需继续进行后续实验才能将其区分。
注:本文依据《GB 4789.5-2012 食品安全国家标准 食品微生物检验 志贺氏菌检验》
注:本文属海博生物原创,未经允许不得转载。
下一篇:肺炎克雷伯氏菌检验



